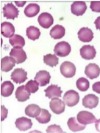
AVATAR

Who´s that pókemon? (sistema C-R en exóticos, EYFII)
|
|
Título del Test:
![]() Who´s that pókemon? (sistema C-R en exóticos, EYFII) Descripción: Estructura y función II |



| Comentarios |
|---|
NO HAY REGISTROS |
|
¿De qiuén es este sistema circulatorio?: "cerrado, con un corazón bicameral: 1 aurícula y 1 ventrículo.". Pez. Anfibio. Reptil. Ave. Mamífero acuático. ¿De qiuén es este sistema respiratorio?: "Su respiración es principalmente branquial, aunque depende de las especies.". Pez. Anfibio. Reptil. Ave. Mamífero acuático. ¿De qiuén es este sistema circulatorio?: "se caracterizan por tener un sistema circulatorio cerrado. Su corazón es tricameral: 2 aurículas y 1 ventrículo.". Pez. Anfibio. Reptil. Ave. Mamífero acuático. ¿De qiuén es este sistema respiratorio?: "Su respiración es principalmente pulmonar, aunque también pueden realizar el intercambio gaseoso a través de piel". Pez. Anfibio. Reptil. Ave. Mamífero acuático. ¿De qiuén es este sistema circulatorio?: "Tienen un corazón tricameral, con septo interventricular incompleto. Para evitar la mezcla de sangre oxigenada y desoxigenada, existe una diferencia de presiones de forma que la sangre no se mezcla nunca.". Pez. Anfibio. Reptil. Ave. Mamífero acuático. ¿De qiuén es este sistema respiratorio?: "La glotis se sitúa bastante rostral y carecen de cuerdas vocales La superficie alveolar para el intercambio gaseoso es el 1% de la superficie de un mamífero del mismo tamaño. Se compone de tres fases: Espiración, inspiración y relajación". Pez. Anfibio. Reptil. Ave. Mamífero acuático. ¿De qiuén es este sistema circulatorio?: "Su sistema circulatorio es cerrado, con un corazón tetracameral proporcionalmente más grande que el de los mamíferos. El tamaño del corazón y las frecuencias cardiacas en reposo varían enormemente según las especies". Pez. Anfibio. Reptil. Ave. Mamífero acuático. ¿De qiuén es este sistema respiratorio?: "Ausencia de epiglotis, anillos traqueales completos, órgano fonador en la carina traqueal, presencia de sacos aéreos y ausencia de pleura. Tienen 10 veces más superficie respiratoria que los mamíferos, y el flujo del aire es a contracorriente del sanguíneo. Además, su respiración es unidireccional, lo que unido a lo anterior aumenta su eficiencia respiratoria.". Pez. Anfibio. Reptil. Ave. Mamífero acuático. ¿De qiuén es este sistema respiratorio?: "Tienen una respiración pulmonar. Inhalan el aire del exterior cuando emergen a través de los espiráculos (orificios nasales), los cuales están cubiertos por una membrana a modo de válvula.". Pez. Anfibio. Reptil. Ave. Mamífero acuático. |